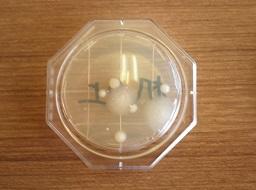

学校の様子(平成29年度)
2/19 校内持久走大会59


ここを曲がると学校まではほぼ一直線という感じです。


長い列になって走って行く子供たちです。


ここら辺が苦しい場所の一つだと思います。



力を抜かず、振り絞る場面です。がんばれ!ファイト!
2/19 県警音楽隊30


突然襲ってきた不審者です。子供たちもビックリ。騒然となります。


そこにおまわりさんが登場しました。犯人と戦います。


おまわりさんが犯人に一撃を加えました。

制圧しました。
2/19 昔の遊び9


羽根つきの子が笑顔です。打てるようになったのでしょう。こっちはけん玉です。


けん玉は最初は皿に乗せようとばかり思いがちです。


でもコツはひざを柔らかく使うことです。


腕を動かさず、ひざで調節するんですよ。
2/19 1年生長峰で凧揚げ2


1月8日に1年生が長峰公園で凧揚げをしましたが、今回はその様子を少し詳しくお伝えします。


風があまりなくても上がる洋風の「カイト」をあげています。


30年位前は、泉小学校の西側の田んぼをお借りして全校生で凧揚げを楽しみました。


所せましと長峰公園を走り回っている1年生の様子がお分かりいただけると思います。明日に続きます。
2/18 5年NHK見学11(最終回)


お昼は宇都宮中央公園で食べました。


少し寒かったのですが、子どもたちはバスの中より外がいいと言ったそうです。


おいしいお昼です。


何かあげていますね。その先には鳩がいました。これでこのシリーズも終了です。長くご覧いただきありがとうございました。
2/18 校内持久走大会58



この角を曲がって東に向かいます。ちょうど上太田方面です。



がんばっていますね。さてこちらはトップです。今、上太田の大江川にかかる橋を北に向かいます。


総合3位の子です。橋を渡ります。そして4位、5位の子も角を曲がって北に向かいます。


6年生2人組が来ました。角を曲がって桜並木を走ります。この桜並木は桜の時期にはそれはそれはきれいな道になりますね。
2/18 県警音楽隊29


県警音楽隊1.mp4
何だか怪しげな雰囲気の人が、子供たちの側に寄って行きます。青い文字をクリックすると動画が見られます。


その不審な人は一体誰なのでしょう?


子供たちが笑って油断をしていると、いきなり帽子を取って武器(かなづち)を持って正体を現しました。


おまわりさんを襲い始めました。
2/18 昔の遊び8


駒が回っています。お家の方が回してくれました。じっと見入る女の子です。


回し方を教わっています。まわす時の姿勢も大事です。


何度も挑戦して回る子が出てきました。こっちは羽根つきです。


3回続くと楽しくなります。
2/18 校内縄跳び大会5(最終回)


高学年の試技です。2回目の試技です。


高学年は2重跳びの種目も入りました。


練習の成果を出しています。そして3回目の試技です。1,2年生です。前跳びです。


3回目の試技は低学年から中学年に移ります。縄跳びは冬の運動として最適です。体育の時間にこれからもどんどん跳んで、体を鍛えていきたいですね。
2/17 5年NHK見学10


最後の体験のグループも無事終わりました。

みんなで記念撮影です。楽しかったですね。


外にはバスが待っていました。乗り込みます。


お昼を食べますよ。
2/17 校内持久走大会57


5年生と6年生は2000mを走ります。



この大会の前まで毎日持久走の練習をしてきました。



そして試走も行ってきました。




今日は自己ベストタイムを目指してみんな走っています。
2/17 県警音楽隊28


会場は大笑いです。二人のお巡りさんのコントの合間の出来事です。


後ろから帽子とサングラスと布をまとった変な人が出てきました。


その格好が面白いので、会場はまた大笑いです。


あんまり大笑いをしていると、この人の格好が覚えられないよ。
2/17 昔の遊び7


外の竹馬遊びの様子です。


お家の人が2人で教えてくれました。この3人はすでに乗れる子かな。


うまいです。ずいぶん歩けますね。


体育館の様子です。これはこま回しの班です。
2/17 校内縄跳び大会4


1月31日に行われた校内縄跳び大会の続きになります。


例年ですと校庭で実施していましたが、今年は校庭は雪で縄跳びには使えませんでした。


そこで急遽体育館に変更しました。狭いですが工夫をしてブロックごとに行いました。


これは3年生と4年生のブロックです。そして次は5年生と6年生のブロックです。
2/16 オリンピックマスコットワークショップ1

今日のふれあい集会(13時~)で5年生が今まで国語の勉強で何時間もかけて準備してきた発表を行いました。

全校生で聞きました。6グループの発表です。5分くらいの発表で一度にやるので、3回発表して3つしか聞けません。ワークショップ方式と呼んでいる発表の仕方です。

この3つのキャラクターを日本の小学生がクラスで一つ選んで投票します。締め切り間近です。泉小の校内投票日は来週の月曜日です。5年生の発表はとても良かったです。ある6年生は「聞いてとっても良かった。」と感想を言いました。なお、このワークショップの様子は後ほどもう少し詳しくお伝えします。
2/16 ハンドベル演奏

昨日のクラブの時間の後半、子どもたちが職員室に来てハンドベルの演奏をしました。


音楽クラブの子どもたちです。


ベル演奏.mp4
曲は「思い出のアルバム」です。上の青い文字をクリックすると動画が見られます。(今回は音は入っていません。)


クラブの時間は限られていますが、一生懸命練習したことが分かる演奏でした。演奏が終わった時、その時いた職員室の先生方から大きな拍手が起きました。
2/16 多読賞表彰


おとといのふれあいタイム(13:25~)で、図書委員会の子が多読賞の表彰を行いました。


泉小学校では読書を推奨しています。図書委員会でもたくさん本を読んでもらおうと、当番制で本の貸出を行っています。


今日は学年で多く本を読んだ友達を表彰しました。


学年でベスト3に入った子どもたちが、前に並びました。図書委員会の子が行った集会でした。
2/16 5年NHK見学9


今度はキャスターがHさんとO君ですね。F君がOKのサインを出せば始まります。


調整室どうですか?「いいです。」と合図ですね。


こっちは音を確かめていますよ。さて今度のキャスターはS君とWさん、お天気はS君ですね。


始まりました。
2/16 校内持久走大会56



第6カメラの画像をまとめてお届けします。上の段左から暫定1位、2,3位、4位です。



この辺りで2000mのおよそ中間地点です。階調に走っている6年生です。



どんどん通過しています。前の人と離れていないと粘りが出ますね。


ここは直線距離で長いコースです。
2/16 県警音楽隊27


黄色い帽子のおまわりさんは、今度は横断歩道の渡り方をやっています。


この様子が滑稽なので、子供たちに大受けです。


子供たちの顔を見れば会場の雰囲気は想像できますね。


相当楽しい雰囲気です。
2/16 昔の遊び6


葉笛の音が聞こえてきました。少しでも音が出ると楽しくなります。


ここはビー玉とおはじきの班です。床で遊んでいます。


そしてお手玉です。投げた玉を受け取れれば面白くなります。


まずは受け取ることです。外では竹馬です。
2/15 3年生表彰1

今日の業間(10時25分~)3年生の表彰を行いました。体育館で全体表彰を2月7日に行ったことはお伝えしましたが、3年生はその時インフルエンザのため学級閉鎖でした。


そのため、3年生がそろった今日の業間に行いました。場所は校長室です。


最初は日本語検定の表彰です。3年生は8名合格しました。


すばらしい成績です。今日家に賞状を持ち帰りました。まだ写真がありますので、後ほどお知らせします。お楽しみに。
2/15 5年NHK見学8


K君とY君がニュースのキャスターです。Iさんが天気予報をしました。


それがモニターに映っていますね。その様子を子どもたちは見ています。


今度は役が替わるようです。O君が天気予報をするようです。


モニターに映るO君です。機械室で確認しています。
2/15 校内持久走大会55

田んぼの中の農道を子供たちは南に向かって走っています。

中川の橋も見えます。PTAの方が安全を守ってくれているのも見えますね。


ズームにしてみました。おまわりさんも見守ってくれています。


交通指導員さんも横断を守ってくれています。パトカーが見えます。
2/15 県警音楽隊26


黄色い金槌で「ポン」、黄色い帽子のおまわりさんは怒られてしまいました。


会場は大笑いです。


高学年の子も大喜びです。


黄色い帽子のおまわりさんは、今度は何をするのかな?
2/15 昔の遊び5


場所の移動をするグループです。遊ぶ場所は多目的ホールと体育館、そして体育館の玄関前の3か所です。


この班は最初は葉笛です。葉っぱを分けてもらいました。


吹き方を習います。説明するのに大きな葉っぱを用意してくれました。


最初はなかなか音は鳴りません。がんばっていますよ。
2/15 5年生国語授業1


昨日の5時間目に5年生が研究授業を行いました。国語の勉強です。


この日は、16日(金)のふれあい集会で5年生がオリンピックマスコットを3グループに分かれて他の学年にPRするので、そのPRをより分かりやすくするためにどうするかを話し合いました。


事前に撮った動画をモニタリングしています。そして自分たちの発表の態度などをチェックしています。


真剣にどこを直せばいいのか話し合っています。まだ写真がありますので、この続きは後ほどお届けします。
2/14 3年生社会科見学1


今日の午前中3年生が社会科見学をしました。今日の見学場所は郷土資料館です。泉小青い目の人形物語「時を超えて」もきちんと展示されていました。


3年生は昔の道具の勉強をします。昔の生活の様子を調べます。


これは何だと思いますか?


これは氷冷蔵庫(こおりれいぞうこ)といって、この中に氷を入れて食べ物を保管したものです。まだ写真がありますので、後ほどお届けします。
2/14 5年NHK見学7


今までのことを確認しています。さて、今度は何をするのでしょう。


O君が天気図の所で見慣れたことをしています。これは栃木県の天気予報です。


こちらはキャスターの席です。カメラマン役の子もいます。


キャスターが交代しました。Iさんはお天気お姉さんの役をやるようです。
2/14 校内持久走大会54


沿道の皆さんの声援は子供たちにとってとっても力になります。


声援を受けながら力を出しています。


がんばって走っている子が近くを通ると思わず「がんばれ!」と言いたくなりますね。


いよいよ外に出ます。交通指導員の方が子供たちの走りを守ってくれています。
2/14 昔の遊び4

集合写真を撮りました。


これからグループに分かれます。グループごとに並びますよ。


だんだん2年生の班長さんを先頭にして整列できています。


先生の注意事項を聞いています。場所の移動が始まりました。
2/14 県警音楽隊25


自分にも貸してほしいち言って、布を借りた今度のおまわりさんは赤い布を腰に巻いて登場しました。後ろの音楽もちょっとユーモラスな曲を演奏しています。


二人のお巡りさん、ずいぶん違う登場でした。


子供たちも笑っていますね。


おやおや、頭に黄色い帽子までかぶってしまいました。
2/13 卒業アルバム個人写真撮影


今日の午前中に卒業アルバムの撮影を行いました。


今日は個人写真の撮影です。


多目的ホールに撮影するための機材がたくさん持ち込まれてセットされています。


写真屋さんは緊張をほぐすように、言葉かけをしながら何枚も撮っていました。
2/13 5年NHK見学6


今度は天気予報の体験です。カメラマンのF君が原稿を見ながら確認します。


音声のS君はヘッドフォンで音の確認です。ミキシングの子達は全体を見ます。


今からミキシングの子が支持を出します。
NHK.mp4
NHK2.mp4
上の青い文字をクリックすると動画が見られます


スタジオ全体の様子です。
2/13 校内持久走大会53


大きな集団がやって来ました。


この辺りは、自分のペースを作って走り始める所です。


試走の時より少しでもタイムを延ばそうとがんばります。


先を見据えて、しっかりした足取りです。
2/13 昔の遊び3


赤鼻のトナカイ.mp4
葉笛で演奏しているのは「赤鼻のトナカイ」です。クリスマスです。


子供たちもよくしっている曲なので楽しそうです。


しっている曲は子供たちの氷上が違います。


葉笛の演奏が終わって2年生の司会者がお礼を言いました。
2/13 県警音楽隊24


「小さな世界」の演奏が終わりました。指揮者の人がお話をしていると・・・・・・・


おや、後ろから何やら表れた人がいます。赤いマントを掛けています。


どうやら変な人の話です。コントが始まりました。


「その赤いマント貸してよ。自分もやりたいな。」と言いながらもう一人の人が腰に巻いて登場してきました。
2/12 5年NHK見学5


いくつかの班に別れた子どもたちです。こっちはカメラの前です。お姉さんに説明を聞きます。


こちらは調整室の子どもたちです。いろいろな機械がありますね。


テレビカメラの下にも時計とモニターがありました。これはニュースを読むモニターの機械です。


こんなふうに写っていますよ。
2/12 校内持久走大会52


カメラが切り替わりました。第4カメラです。先頭集団は3人です。第2集団が追っています。


大江川沿いの道路です。選手の左手はスクールバスです。


天気は快晴。風がややあって、冷たい風です。


風に負けないでがんばれ。高学年は2000mを走ります。
2/12 表彰集会後半


水曜日の表彰集会の続きです。青い目の人形物語「時を超えて」の感想文の表彰です。左は2年生のOYさん、右は4年生のIHさんです。


続いて4年生SY君、そして4年生YYさんが表彰されました。


歯科の「歯と口の健康週間」の作品賞です。6年生のTMさんが代表です。続いて日本語検定の認定証です。6年生のSMさんが表彰されています。


次は5年生のYR君、そして5年生HYさんが賞状をもらいました。


2年生のSSさん、2年生のYT君です。日本語検定試験合格おめでとうございます。3年生が欠席ですが全員で16名が合格しました。
2/12 県警音楽隊23


小さな世界(ちいさなせかい、原題: “It’s a small world”)は、世界各地のディズニーパークにあるアトラクション「イッツ・ア・スモールワールド」のテーマソングです。少し調べて見ました。


今日世界中で歌われ続けている童謡の一つであり、同時に「ミッキーマウス・マーチ」「星に願いを」と並んでディズニーを象徴する代表的な曲として知られています。


同じくディズニーの、OVA作品「ライオン・キング3 ハクナ・マタタ」「ラマになった王様2 クロンクのノリノリ大作戦」にも使われているそうです。前者では主人公ティモンが歌い、後者ではBGMだそうです。


東京ディズニーリゾートの最寄り駅である、JR京葉線舞浜駅(新木場・東京方面行き2番線)の発車メロディとして2004年6月14日より採用されていると言います。また、東武伊勢崎線太田駅7・8番線では、出発信号機が開通した際のメロディに使用されているようです。
2/12 県警音楽隊22


次に流れてきた曲は「小さな世界」です。ディズニー映画で有名です。少し歌詞を紹介しましょう。


1 世界中どこだって 笑いあり涙あり みんなそれぞれ助け合う 小さな世界


*世界はせまい 世界はおなじ 世界はまるい ただひとつ


2 世界中誰だって 微笑みあえば仲良しさ みんな輪になり手をつなごう 小さな世界
*世界はせまい 世界はおなじ 世界はまるい ただひとつ
2/11 5年NHK見学4


今度は実験です。3人がカメラの前に立ちます。すると普通にモニターにも映ります。


でもこの青い布を体の前にすると、モニターには顔しか写っていませんね。


今度は子どもたちをいくつかの班に分けました。こちらは調整室です。「あ、写ってる。」


そしてこちらはテレビに映る机の前です。こっちは天気予報をするモニターのコーナーです。
2/11 校内持久走大会51


長い列ができていますね。


この辺りはスタート約700mぐらいでしょうか。


表情にまだ余裕が感じられます。


これからは道路ですよ。
2/11 5年生家庭科ミシン後半


ミシンは使い方が分かって、何度も練習して初めてできるようになります。

子どもにとっては理屈ではなく、体験が重要なのです。


ですからこれだけボランティアの方々が教えてくれると、待ち時間もなくたくさんの練習ができます。


泉小ではできるだけ、ボランティアの方々の協力をお願いしています。


地域の方そしてお年寄りの方ともとも仲良くなれるいい機会でもあります。
2/11 県警音楽隊21


「聖者の行進」はアメリカ合衆国のニューオーリンズの曲です。この曲を調べて見ました。


現在は、スポーツにおいて応援歌として使われることも多く、NFL(アメリカのフットボールボールリーグ)のニューオーリンズ・セインツのオフィシャルソングであり、サッカーのプレミアリーグのサウサンプトンFC(愛称がセインツ)のアンセムなどにもなっています。


日本国内ではBCリーグの群馬ダイヤモンドペガサスがチャンステーマ1として使用しているそうです。


映画『5つの銅貨』(1960年)でこの曲が使用され、ルイ・アームストロングとダニー・ケイの歌ったこの曲が有名になった。
2/11 県警音楽隊20


答えはその通りショクパンマンでした。耳があるから聞こえるんですね。


正解でした。


さて次は音楽です。曲は「聖者の行進」です。


聞いたことがある子がいるようです。
2/10 卒業アルバム委員会撮影2


体育委員会の卒業アルバム撮影の様子です。カメラ屋さんが撮影していますね。

こんなポーズもとってみました。


こちらは飼育・栽培委員会です。玄関でミヤコタナゴの水槽の前で撮りました。

子どもたちはミヤコタナゴの世話を当番で毎日行っています。ミヤコタナゴは今元気に育っています。
2/10 5年NHK見学3


SR君がニュースを読んでいる所が分割画面でモニターに映っています。お姉さんと打ち合わせをしています。


読む原稿はここに写っています。少し緊張しているSR君です。


お姉さんが説明を続けます。「みんなにことがこのモニターに写ってますよ。」


子どもニュースに登場したのは今度はこの3人です。K君、S君、そしてHさんです。
2/10 校内持久走大会50


バックストレートのカメラがとらえた子供たちの様子です。2週目です。


カメラが切り替わりました。第3カメラです。プールの西の角からとらえています。ズームで撮っています。先頭集団が学校から道路へ出る場面です。


暫定通算5位の5年生の子です。今度は大きな集団です。7位くらいのつけています。女子の先頭集団です。


その次の子がきました。どんどん道路へ出て行きます。
2/10 5年生家庭科ミシン前半


1月18日に5年生が家庭科でミシンの勉強をしました。そのことをお伝えします。


この日はボランティアの方を学校にお願いしました。


すると5人の方がボランティアとして学校に来て子どもたちにミシンの使い方を教えてくれました。


ミシンは数はあるのですが、教えてくれる人がいないとなかなか進みません。明日に続きます。
2/10 県警音楽隊19


次の問題がおまわりさんから出ました。


「アンパンマンとショクパンマンとカレーパンマンのうち音が良く聞こえたのは誰でしょう?」


手が挙がり始めました。


いっぱい手が挙がりました。そして指名された6年生が答えました。「耳があるからショクパンマンです。」
2/10 県警音楽隊18


「りんごは赤、そして止まれの色です。」子供たち良く聞いています。


今度は「警察のマスコットの色は何色ですか。」青ですね。青は進んで良いです。


「これは何色ですか。」子供たちが一斉に答えました。「あか~~~~!」


でもこれは青ですね。子供たちは引っかかって苦笑いです。
2/9 6年生木工教室1


今日の午前中、6年生が木工教室の勉強をしました。


1時間目から3時間目まで図工の時間です。卒業記念の小箱を作りました。


ボランティアの方が5人来てくれて、子どもたちの教えてくれました。


子どもたちの感想はどの子も「楽しかった。」でした。子の様子は後ほど詳しくお伝えする予定です。
2/9 5年生NHK見学2


2回目の今日は再び会議室に入った5年生はNHKや放送について説明を受けました。NHKは日本放送協会の頭文字ですね。


子どもたちは熱心にメモを取っています。


違ったカメラの写真です。今度はビデオで説明を聞きます。放送で大切なことは、①早さ ②正確さ ③分かりやすさ だそうです。


今度はスタジオで体験します。こどもニュースを体験しているS君です。
2/9 校内持久走大会49


カメラが切り替わりました。第2カメラがとらえています。バックストレートです。半周目の様子です。


桜の冬姿の下を駆け抜けます。


2週目に入っています。先頭集団は6人です。第2グループが来ました。


応援してくれる人の数も多いですね。
2/9 昔の遊び2


早速葉笛の演奏が始まりました。「葉生音(はぶね)の会」の皆さんの演奏です。


葉笛演奏(青い目の人形).mp4
泉小学校に青い目の人形があるので、わざわざ選曲してくださいました。上の青い文字をクリックすると動画が見られます。


子供たちよく聞いています。


どうして音が出るのかな?不思議です。
2/9 県警音楽隊17

今度は地元の駐在所のおまわりさんのお話です。


何だか大きな紙袋を持って来ました。


子供たちは「何が始まるんだろう。」と興味深そうです。


紙袋から出てきたのは赤いリンゴの絵です。
2/8 卒業アルバム委員会撮影1


6年生も卒業を控え、アルバムの撮影をする時期になりました。今日は6時間目に委員会の撮影をしました。上は保健委員会です。保健室での撮影です。


この写真は企画委員会でrす。毎朝あいさつ運動の中心で活躍している場面を撮りました。もう少し写真がありますので、後ほどお届けいます。
2/8 1年生長峰で凧揚げ1

今日の午前中、1年生が長峰公園に行って凧揚げを楽しみました。


今日はしばらくぶりで暖かい日になりました。風もなかったので、担任の先生に聞いたら「良く上がりました。子どもたちは走りながら楽しんでいました。」と話しました。


子どもたちの様子がもう少し写真にありますので、後ほどお伝えします。
2/8 保健室掲示2月-4(最終回)


それぞれの場所の実験結果が出ました。


この日の一番細菌が多かったのは、机の上です。そのこと分かりやすく掲示してあります。


掃除の子どもたちは掲示を見ています。


「こんなに最近がいるんだな。」これを見ながら話していました。
2/8 校内持久走大会48


今日は、スタート直後から半周を走って行く場面をお届けします。


混乱もなく、転んだ子もいません。


トラックのコーナーをきれいに並んで走っています。


保護者の方の車の横を走っています。そしてバックストレートに入りました。
2/8 昔の遊び1


昨年12月に行った昔の遊びのシリーズを始めます。


1年生と2年生が毎年行っている遊びです。


地域に住むお年寄りや、子供たちのおじいちゃんおばあちゃんに来てもらいました。


2年生が開会式の司会をして今年も昔の遊びが始まりました。
2/8 6年生青い目の人形授業13(最終回)


授業の終末の様子です。グループで話し合って見つけた答えを発表しています。


「どうして青い目の人形は、処分されたのだろう?」


子供たちは答えます。そして誰かが「でっかい戦争」という言葉を言いました。


「日本とアメリカででっかい戦争をしたから。」と今日見つけた答えを書きました。そしてその次の時間から、社会科で日本が歩んだ戦争の道を子供たちは勉強して行きました。
2/7 表彰朝会前半


今日の集会(13:30~)は表彰集会を行いました。最初は書初め展の表彰です。6年生TMさんが代表です。今日はインフルエンザが流行っているため、子どもたちは全員マスクをしています。


そして次は塩谷地区理科展覧会の表彰です。6年生のSAさんが代表です。次は学校教育書写書道作品展の表彰です。5年生のHS君が受賞しました。


次は青い目の人形物語「時を超えて」感想文の賞状です。2年生3名、4年生5名が受賞しました。最初は2年生のHS君です。


次は4年生のHT君です。そして2年生のSSさんです。この続きは後ほどお届けします。
2/7 租税教室後半


税金のことは身近でないことが多いので、この日は6年生はいろりろ考えたようです。そのいくつかをノートの文章で紹介します。


児童1 ニュースで消費税を10%にすると言ってたけど、なんで高くするのかと思ったのですが、今日の授業をして国民のためになるならあげてもいいかなと思いました。


児童2 まさか税金を払わないと、道路の補修費やごみの回収がなくなってしまうとは思いませんでした。


児童3 火事が起きたときに水も使えないし、多額の賠償金も払わなくちゃならなくなるなんて、大変だしいろいろな場面で生活も苦しくなると思いました。
2/7 保健室掲示2月-3


今度は細菌がどこにどれくいいるのか調べる実験をしました。細菌を培養する容器です。容器のビニルの表面にマジックで「机の上」「手のひら」「ドアノブ」と描きました。最初はビニルをはがして手のひらにスタンプのようにちけます。


こっちは机の上の細菌を調べます。ドアのとってのもつけてみます。


こんな感じでとれました。そしてまた新聞の上に置きました。

保温してしばらく調べます。細菌が繁殖しました。一つの細菌がコロニーを作って大きく成長します。
2/7 ドライアイスの授業11(最終回)


3年生も一緒になって理科の実験が始まりました。時々味見をしながらやっています。


オレンジシュースを入れた班もあります。


シャーベットがどの班もできあがりました。これでこのシリーズも終わりになります。
2/7 校内持久走大会47

スタート直前です。スタートまでの様子を連続の写真でご覧ください。

「位置について!」

「スタート!」

一斉に走り出しました。混乱もありませんね。良いスタートが切れました。
2/7 県警音楽隊16


3曲目は「ドラえもん」です。み~んな知っている曲ですね。


その後はお話がありました。


県警音楽隊のマークが入った譜面台が見えます。


副隊長の方が司会者になってお話が始まりました。
2/6 3年生学級閉鎖

3年生がインフルエンザBでの欠席者増加のため、明日から3日間学級閉鎖とします。


3年生は臨時閉鎖期間中は学童も出席停止になります。外出せず、家庭で過すようにしてください。担任から3日間の学習や生活について指導があります。プリントも出ますのでご確認ください。


他の学年もうがい、手洗いの徹底をお願いします。3年生の次の登校は来週の火曜日になります。
2/6 5年生NHK見学1


今日の午前中、5年生がNHKの見学に行ってきました。最初に会議室で見学の予定を聞きました。


それから外に行って中継車の見学をしました。係の女の人が説明をしてくれました。


説明を聞きながらメモを取る5年生です。見上げています。


それから屋上に上がりました。そして電波塔を見ました。高いです。この続きは後ほどシリーズとしてお届けします。
2/6 保健室掲示2月-2


保健室での実験の結果は明らかに分かりますね。ペットボトルの上下に窓を明けたものが空気の流れが良くなります。このことを朝の時間に保健委員会の子が各クラスに行って説明してきました。


よく分かるように話すのは大変でしたね。


このクラスでも説明しています。だからこんなふうに休み時間には窓を開けるのが良いですね。
2/6 ドライアイスの授業10


4年生の授業を3年生が見に来ました。なんだかおそるおそる3年生が入って来ましたよ。


そしてコップのカルピスを混ぜるのをやり始めました。


少しなめた班がありました。「あ、カルピスだ。」


カルピスがシャーベットになりました。
2/6 校内持久走大会46


スタート2分前。少しずつ表情のモードが変わってきました。


後ろにいる子供たちの表情もとらえています。


スタート1分前です。スタートラインに着きました。


間もなく合図がなりますよ。1年生と2年生の様子です。
2/6 県警音楽隊15


1曲目のシエラシスターという曲が終わり、音楽隊副隊長の方がお話しています。


次の演奏曲は「大きな古時計」です。「お~きな のっぽの 古時計 おじいさんの 時計」で始まる曲ですね。


子供たちもよく知っている曲が演奏されました。


心の中で歌っている子もいると思います。
2/5 6年生租税教室前半


今日の5時間目に6年生が「租税教室」の勉強をしました。市役所の方が説明をしました。


プリントを見て、子どもたちは税金が必要か、入らないかを考えました。


どんな物が税金で作られているのか確認しました。


その後、市役所の方がビデをを見せてくれました。次回に続きます。
2/5 保健室掲示2月-1

今日から保健室掲示が変わりました。タイトルは「冬だからこそ窓をあけよう」です。


保健委員会の子と養護の先生が実験したことも写真入りで説明されています。


ペットボトルで煙を充満させて、どのように穴を開けると早く煙がなくなるかを実験しました。


左はペットボトルの上と下の反対側に窓を開けました。もう一つは同じ高さに明けました。窓の高さは上の方になります。続きは明日お届けします。
2/5 校内持久走大会45


さて、今日から5,6年生の持久走大会の様子を詳しくお伝えします。


スタート5分前です。まだ表情にはゆとりが見られますね。笑顔の子もいます。


距離は2000mになります。


試走もしたし、後は自分の記録との戦いになります。
2/5 6年生青い目の人形授業12


子供たちが話し合っているのは、「どうして青い目の人形は処分されたのだろう。」です。


子供たちは、今日調べたことを元にして友達と考えを話しています。


なんとなく分かっていたり、気づいていても言葉にするのは難しいことです。


分かった班からノートに書いていますね。
2/5 臨海自然教室43(最終回)


最後に退所式をやりました。ホールに集合して行います。


自然の家の先生が来てくれました。泉小の代表の子があいさつをしました。


「ありがとうございました。」自然の家の先生から「きまりを守って良くできました。これから学校の生活で役立ててください。」とお話がありました。


11月17日13時過ぎの太平洋です。波もなく穏やかですね。5年生は無事学校に帰って来ました。大きく成長した5年生です。これで臨海自然教室のシリーズも終わります。長い期間ご覧いただきありがとうございました。今度は6年生を送る会を計画している5年生です。きっと心がこもった送る会ができると思いますよ。
2/4 ドライアイスの授業9


子供たちはカルピスをコップに入れて、その中にドライアイスを入れています。


そしてそのコップの中をかき混ぜます。


あまり変化は起こりません。


ドライアイス8.mp4
ドライアイス9.mp4
でも、あれ、何だか変だよ。ちょっと固まってきたみたい。上の青い文字をクリックすると動画が見られます。
2/4 校内持久走大会44


ゴールをした3年生と4年生の子供たちです。


持久走の素晴らしさを感じました。試走を何度かしているので、その時のタイムは先生から知らされています。


自分の記録と戦う事が一番自分自身にとっても良いことだと思います。

中学年の子もどの子もがんばった持久走大会でした。
2/4 臨海自然教室42


3日目のお昼の時間です。大きな開口部のガラス窓から太平洋がよく見えます。


海浜自然の家の学習が全て終わりました。


楽しい3日間でした。疲れもあるでしょうが、子供たちには貴重な体験がたくさんありました。


規律の正しい生活も5年生はみんなきちんと守れました。
2/4 日産工場の見学4(最終回)


みずほの公園は全国都市緑化フェアの時に整備された公園です。


マロニエ栃木綠化祭2000を開催した場所です。


「みんなの広場」「せせらぎ広場」「バーベキューパーク」などを整備して平成19年に正式オープンしました。


お昼を食べ、昼休みを楽しく遊んでバスに乗って帰って来ました。
2/3 ドライアイスの授業8


ドライアイス6.mp4
ドライアイスの白い煙が出てきたところにシャボン玉を吹きかけます。


あんまり上手には出来ませんでしたが、こんな感じにふくらみました。


次にやるのは何でしょうか。カルピスをコップに入れていますね。


そのカルピスが入ったコップにドライアイスの砕いたものを入れました。
2/3 校内持久走大会43




持久走は、自分との戦いです。最後までがんばった子供たちの顔はみんな素晴らしいですね。



最後まで粘って粘った結果です。全員完走できて3,4年生もとても良かったです。


走り終わった子たちは、校庭を約半周歩いて、座ります。


どの子もほっとした表情ですね。
2/3 臨海自然教室41


焼きいもを食べている子供たちです。炭火で焼いたのでまた格別なおいしさです。


そう言えば茨城県はさつまいもの生産が盛んです。


ほくほくのさつまいもを食べ、塩作りもうまくいって満足そうです。


良い経験ができましたね。
2/3 日産工場の見学3


工場の見学がありましたが、写真撮影は禁止です。ですから子供たちの感想を紹介します。


「ふだんは見られない組み立て工場がどうなっているのか知れて良かった。」


「ぼくが気になっていたGT-Rやフーガなどが近くで細かく見られたので良かったです。また作るときの工程が知れて良かったです。」


工場見学の後、お昼を食べに近くの「みずほの自然森林公園」に来ました。
2/2 3度目の雪


昨夜からの雪が約8㎝積もりました。ことし3度目の雪です。職員も雪かきに大忙しです。


体育館の方から来る、平野、下伊佐野、田野原地区の方面も、東昇降口も通路の確保をしました。


えのきがあるの正門方面の東泉の子どもたちの通路もきれいにしました。早く来た6年生もお手伝いです。


スクールバスの通路の確保しておきました。間もなくスクールバスから降りてくる子どもたちです。


今日も雪ですが元気に登校できた子どもたちの一日は始まります。
2/2 縄跳び大会3

高学年の部が始まりました。


縄跳び高学年1.mp4
縄跳び高学年2.mp4
前跳びは4分間の試技になります。上の青い文字をクリックすると動画が見られます


まだまだ多くの子が余裕を持って跳んでいます。


座り始めた子が出てきました。緊張するとひっかかってしまいます。慎重にやってください。
2/2 校内持久走大会42



3年生のゴールシーンが続きます。


ゴールの瞬間はいいものですね。



完走できたという満足感はかけがえのないものです。


自分の努力でつかんだ満足感ですね。
2/2 6年生青い目の人形授業11


友達と相談しながら調べると楽しく勉強できます。


「ここだよね。」「あ、そうか。」 「ねえ、ここ見て。」「どれどれ。」


「あ、見つけた。」 「本当だ。」


「ここに書いてあったよ。」「ありがとう。」「ここ、そうじゃない?」
2/2 臨海自然教室40


海水からの塩作りも楽しくできたようです。こんどは片付け、洗い仕事です。


使った物は最初の時と同じくらいきれいにして返します。


水は冷たかったようでしたが、がんばってぴかぴかにしました。子供たちが塩作りをしている間に焼き芋ができました。


自然の家の先生が、専用の壺で作ってくれました。炭で焼いた焼き芋です。
2/1 縄跳び大会2


縄跳び3,4年生1.mp4
縄跳び3,4年生2.mp4
今日は縄跳び大会の2回目、3年生と4年生です。


この写真は4年生です。横で応援しているのは1,2年生です。ステージの上ではタイマーが動いています。


前跳びが順調に進んでいますね。後ろの報の年生もがんばっています。


ステージの上では5,6年生が応援しています。
2/1 1年生Englishlesson


1年生のEnglishlesson(13時50~14時)の時間の様子です。


曜日の勉強です。月曜日と火曜日と水曜日がカタカナか書いてありません。歌で覚えています。


lesson1年生English.mp4
歌で覚えた後は、アクティビティーです。目を閉じて先生の言うとおりにします。先生は英語で右、左、などを言います。


7回くらい言いました。逢っているでしょうか。目を開いた時に南の窓を向いていた人は正解です。
2/1 ドライアイスの授業5


ドライアイス5.mp4
下のビーカーには砕いたドライアイスが入っています。そこに今、水を入れようとしています。煙が出て来ましましたよ。上の青い文字をクリックすると動画が見られます。


もくもくと煙が出て来ました。その煙をろうそくの炎にかけると、火がすぐに消えてしまいました。ドライアイスは物を燃やす働きがないのです。


今度はこのドライアイスの煙に向かってシャボン玉を吹きかけます。


「もう一度水を入れるよ。」と先生がビーカーの水を足しました。子供たちはシャボン玉を作ろうとその煙に向かって吹きかけています。
2/1 校内持久走大会41


さてどの子も頑張りを見せて学校に帰って来ました。


カメラは切り替わりました。第2カメラです。ゴールシーンを集めてみました。4年生の決勝の瞬間です。最後まで良い勝負をしました。素晴らしい戦いでした。


こちらは3年生の優勝の瞬間でした。最後まであきらめませんでした。これも素晴らしいです。



3年男子3位。そして4年男子3位。続けて3年女子1位がゴールしました。特に3年女子の優勝は大会新記録でした。おめでとう。
2/1 臨海自然教室39


塩が出てきました。最後は火から土鍋を外します。余熱で十分です。


まだ相当に土鍋も塩も熱いので、手袋をして作業します。


水分が余熱でほとんどなくなったら、スプーンで土鍋の中央に塩を集めます。


こんな様子で塩を作っています。
1/31 縄跳び大会1


縄跳び大会1.mp4
縄跳び大会2.mp4
今日のふれあいタイム(13時25分~)校内縄跳び大会を行いました。上の青い文字をクリックすると動画が見られます


校庭が雪で使えないので体育館で行いました。最初は1,2年生の番です。


初めは前跳びを跳びました。次は後ろ跳びです。


記録を担任の先生が取っています。体育の時間にも縄跳びをやっているので、その成果が出ればいいですね。もう少し写真がありますので後ほどお届けします。

